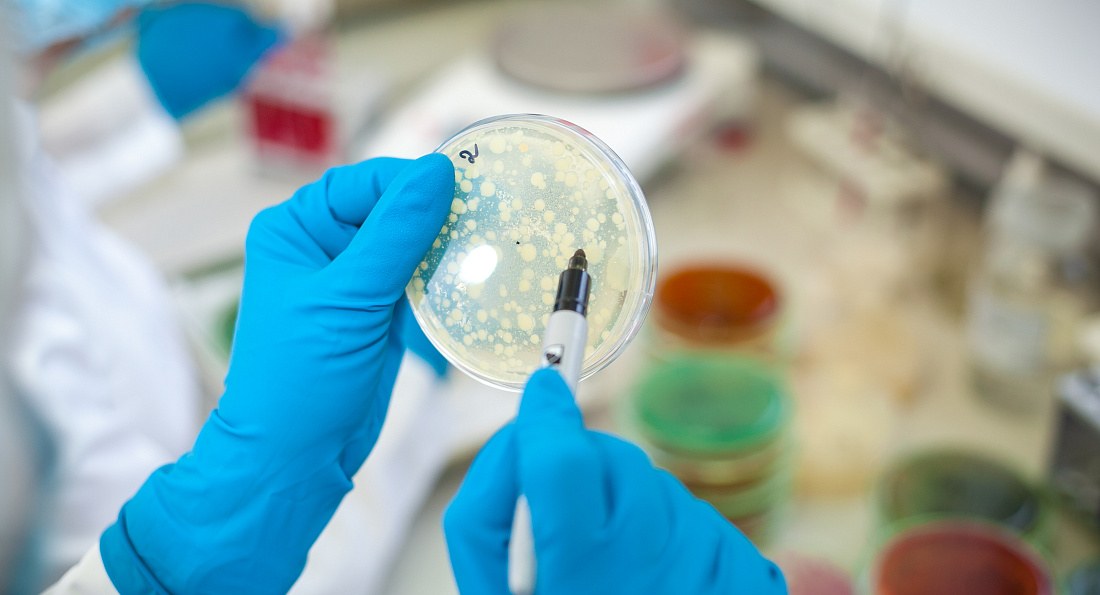

Специалисты Кабардино-Балкарского пункта выявили небезопасное мясо птицы
В рамках пищевого мониторинга специалисты отдела ветеринарно-санитарной экспертизы Кабардино-Балкарского пункта Северо-Кавказского филиала ФГБУ «Центр оценки качества зерна» провели исследование пробы мяса птицы в целях установления качества и безопасности продукта.
По результатам проведенных испытаний выявлено превышение нормы по КМАФАнМ (количество мезофильных аэробных и факультативно-анаэробных микроорганизмов), что не соответствует требованиям технического регламента Таможенного союза по показателям безопасности продукции.
Информация о полученных результатах внесена в автоматизированную систему «Веста» и направлена в Северо-Кавказское межрегиональное управление Россельхознадзора для принятия соответствующих мер.
Для потребителя показатель КМАФАнМ характеризует качество, свежесть и безопасность продуктов питания. Он позволяет оценивать уровень санитарно-гигиенических условий социальной сферы на производстве, выявлять нарушения режимов хранения и транспортировки продукта.
Такие нарушения могут привести к пищевым отравлениям. Особенно уязвимы дети раннего возраста, пожилые люди и лица с ослабленным иммунитетом. Поэтому лабораторный контроль продуктов питания – важный этап обеспечения пищевой безопасности потребителя.